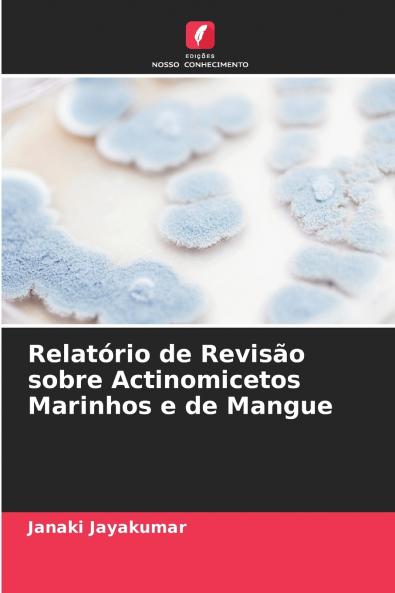
Relatório de Revisão sobre Actinomicetos Marinhos e de Mangue

Portuguese
Paperback
₹4364
(All inclusive*)
Delivery Options
Please enter pincode to check delivery time.
*COD & Shipping Charges may apply on certain items.
Review final details at checkout.
Looking to place a bulk order? SUBMIT DETAILS
About The Book
Description
Author
Os actinomicetos que crescem em ambientes altamente salinos representam uma fonte importante de compostos biologicamente activos. Muitos compostos antibacterianos antifúngicos antitumorais citotóxicos e fotoprotectores foram isolados destas áreas. Os actinomicetos marinhos e dos mangais podem ser uma fonte de medicamentos com uma nova química e um potencial promissor. Uma vez que as áreas marinhas e de mangais estão intimamente relacionadas entre si consolidei aqui o trabalho de investigação efectuado por outros investigadores relacionados apenas com esta área. O presente trabalho consolidou os relatórios disponíveis sobre diversidade atividade antagonista caraterização fisiológica e bioquímica sequenciação de 16sRNA e análise filogenética compostos bioactivos atividade anticancerígena atividade antioxidante atividade larvicida de mosquitos atividade de queratinase e acumulação e degradação de metais pesados. Garanto-vos que este relatório de revisão poderá ajudar a dar uma nova dimensão ao vosso estudo dos actinomicetos marinhos e dos mangais. Agradeço a todos os investigadores que realizaram um trabalho maravilhoso neste domínio emergente para melhorar o fornecimento de medicamentos a partir de actinomicetos marinhos e de mangais e também pela sua contribuição para a nossa sociedade.
Delivery Options
Please enter pincode to check delivery time.
*COD & Shipping Charges may apply on certain items.
Review final details at checkout.
Details
ISBN 13
9786208756222
Publication Date
-18-03-2025
Pages
-76
Weight
-116 grams
Dimensions
-152x229x4.62 mm